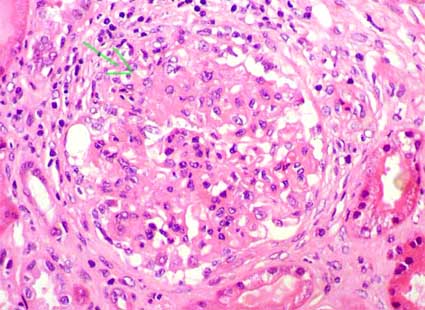

Homepage - - - Tutorial Index
Lupus nephritis and renal involvement in other rheumatologic diseases
Lupus nephritis - Rheumatoid arthritis - Mixed connective tissue disease - Progressive systemic sclerosis - Sjögren syndrome
Systemic lupus erythematous (SLE) is a multisystemic disease in which there is production of autoantibodies and immune complexes formation. The antibodies can be directed against many nuclear antigens (ANAs), including DNA, nuclear ARN, and proteins; or against cytoplasmic or cellular membrane antigens. The immune complexes can be deposited or formed in diverse tissues, activating the complement and releasing proinflammatory cytokines that produce tissue damage. The diagnosis of SLE requires correlation of clinical and laboratory findings; there is not an only test or clinical finding that allows to confirm it and only a renal biopsy does not permit to make the diagnosis. The reviewed criteria for diagnosis are based on the 2019 European League Against Rheumatism/American College of Rheumatology Classification (EULAR/ACR) Criteria (Aringer M, et al. 2019 European League Against Rheumatism/American College of Rheumatology classification criteria for systemic lupus erythematosus. Ann Rheum Dis. 2019;78(9):1151-1159 [PubMed link]), this classification includes positive ANA of ≥1:80 at least once as obligatory entry criterion; followed by additive weighted criteria grouped in 7 clinical (constitutional, hematologic, neuropsychiatric, mucocutaneous, serosal, musculoskeletal, renal) and 3 immunologic (antiphospholipid antibodies, complement proteins, SLE-specific antibodies) domains, and weighted from 2 to 10. Patients accumulating ≥10 points are classified as SLE. Thus, specifically, if a patient has proliferative glomerulonephritis (focal or diffuse, mediated by immune complexes - "full-house" pattern) and positive ANA would already have SLE criteria. In the validation cohort, these criteria had a sensitivity of 96.1% and specificity of 93.4%.
The etiology of the disease is not well-known. Genetic, infectious, hormonal, and other environmental factors seem influence on its pathogenesis. Some cases are related to hereditary deficiencies of the complement and others can be induced by drugs. The development of autoimmunity has been attributed to inadequate elimination of autoreactive lymphocytes. A dysregulation of the apoptosis and inadequate removal of apoptotic cells and nuclear rests seem important in the pathogenesis (Stuart L y Hughes J, Nephrol Dial Transplant 17:697, 2002 [PubMed link] [Free-Full-text]). The renal damage can be secondary to activation of the complement and local liberation of proinflammatory cytokines. Some intrarenal antigens, like components of the extracellular matrix and glycoproteins, can serve as target of the autoimmune attack. Deposition of circulating immune complexes with local activation of inflammation is another recognized mechanism of tissue damage. In addition, antiphospholipid antibodies can promote thrombosis or vascular injury. In lesions with membranous features (class V) there is cytotoxic injury of podocytes by antibodies and complement.
Lupus nephritis is a type-3 hypersensitivity reaction. This occurs when immune complexes are formed. The characteristics of the autoantibodies in relevance to lupus nephritis are: i) Anti-dsDNA antibodies may cross-react with the glomerular basement membrane; ii) Higher-affinity autoantibodies may result in intravascular immune complexes that get deposited in glomeruli; iii) Cationic autoantibodies have a greater affinity for the anionic basement membrane; iiii) Activation of complements by autoantibodies of certain isotypes These autoantibodies make immune complexes within the vessels that are deposited in glomeruli. Alternatively, autoantibodies may form immune complexes in situ by binding to antigens that are already located in the glomerular basement membrane. Immune complexes induce an inflammatory response by the activation of the complement system and recruitment of inflammatory cells. Glomerular thrombosis is another phenomenon that plays a part in the pathogenesis of lupus nephritis particularly in patients with antiphospholipid syndrome and is believed to be the result of an interaction between antibodies and negatively charged phospholipid-proteins. (Musa R, Brent LH, Qurie A. Lupus Nephritis. 2021 Aug 6. In: StatPearls [Internet]. Treasure Island (FL): StatPearls Publishing; 2021 Jan–. PMID: 29762992.[PubMed link]).
There is renal involvement in the great majority of patients with SLE at some time of the evolution: 66-90%. The presence of subendothelial deposits in glomerular capillaries is crucial in the induction of severe damage and they correlate with endocapillary proliferation, necrosis, karyorrhexis and crescents. Renal disease is one of the most frequent causes of death in SLE and it is one of the alterations that more attention must receive on the patients’ treatment.
Clinical features: The disease appears in an ample age range, but it is more frequent in young adults; the relation man: woman is of 1:9 and there is greater incidence in Afro-American than in Caucasians.
Extrarenal manifestations are ample and variable, and include alterations of the skin, joins, heart, lung, hematologic (cytopenias), neurological (convulsions, psychosis, peripheral nervous system involvement), mucous (ulcerations), serositis, and so on.
Renal manifestations are also very variable, from asymptomatic hematuria or proteinuria until rapidly progressive renal failure and terminal renal damage. In some cases lupus nephritis presents like a nephrotic syndrome (in until 65% of cases) and in others like a nephritic syndrome. Renal failure is a relatively frequent clinical presentation; it can be due to glomerulonephritis (GN) or due to acute tubule-interstitial damage; in these cases the lesions are potentially reversible. Renal disease is, sometimes, the initial manifestation of SLE, and it even can for a long time precede the affectation of other organs or systems. When the clinical findings are mild hematuria and/or proteinuria the renal lesions usually are mesangial (classes I or II); when the disease presents like nephritic syndrome with some degree of acute or rapidly progressive renal failure usually there are active glomerular lesions (classes III or IV); when it appears as pure nephrotic syndrome is frequent to find glomerular lesions with membranous features (class V); and when there is chronic renal failure we will find probably sclerosing advanced lesions (class VI). Nevertheless, again, the clinical and histopathologic presentation are very heterogeneous and the clinical and laboratory findings do not allow predicting with certainty the type and degree of renal damage.
The survival of patients and the preservation of the renal function have improved in the last decades. The treatment is based on corticosteroids and other immunosuppressors. The renal disease is one of the main causes of death in SLE. When chronic renal failure is developed and hemodialysis is started the extrarenal manifestations improve in many patients. Renal transplantation is a good therapeutical option in cases of terminal damage; recurrence of the disease in the graft is not very frequent and the survival of the transplant is similar to the one of other patients; immunosuppression that receives the transplanted patients is, at least partly, the responsible for the clinical improvement in SLE.
Laboratory findings: In many patients there is proteinuria in a variable range, usually accompanied by hematuria, sometimes with erythrocyte casts. When there are active glomerular lesions we can find casts of leucocytes. The serum levels of creatinine and BUN will be altered (or not) according to the type and severity of the renal lesions, in general, there is increase of the levels in cases of active lesions (classes III and IV) or chronic damage. In many cases of mesangial lupus nephritis and pure membranous GN (class V) the renal function is preserved. There is hypocomplementemia in most of patients with active disease, and, at least in some, complement levels correlate with the activity of the renal disease. There is a variety of autoantibodies that can be detected in the serum: ANAs, anti-dsDNA, anti-Sm (very specific but few sensible), anti-RNP, anti-Ro, anti-La, anti-histona, and others; anti-DNA antibodies seem important in the pathogenesis of the active lupus nephritis.
Histopathology
Glomerular changes are highly variable. The commonest alteration is the presence of mesangial and/or capillary immune deposits. Other changes include: increase of the matrix and/or mesangial cellularity, endocapillary proliferation, thickening of capillary walls, glomerular tuft necrosis, extracapillary proliferation (crescents), karyorrhexis, hyaline thrombi (micronodular intracapillary aggregation of immune complexes), and glomerular sclerosis (segmental or global). Some features are suggestive of lupus nephritis: hyaline thrombi and “wire loop” lesions (homogenous and “rigid” thickening of peripheral capillary loops due to subendothelial immune deposits), nevertheless, the only alteration considered by many authors as pathognomonic of lupus nephritis are the hematoxylin bodies: they are rounded, smudgy, lilac-staining structures, seen as cells with degenerated aspect; probably they represent degenerated nuclei and correspond to LE cells described in the blood of patients with SLE (figure 4); it is very unusual to find them at the present, reason why its utility is very limited (sensitivity near 2%). The variability in the presence, combination and extension of these lesions permit to classify lupus nephritis based on histologic aspects (Figures 1, 2, 3, 4, 5, 6, 7, 8, 9, 10 and 11).
Figure 1. Glomerular tuft with proliferation of mesangial cells, segments with endocapillary proliferation, and a small circumscribed crescent (arrow). In lupus nephritis active proliferation and glomerular changes are frequently segmental; nevertheless, to determine if it is class III (focal) or IV (diffuse) it is necessary to quantify the percentage of glomeruli with lesions (H&E, X400).

Figure 2. Necrotizing lesions of the glomerular tuft indicate severe immune aggression in lupus. The necrotizing segments (red arrow) appear fuchsinophilic with the trichrome stains, and they are accompanied by distortion of the tuft and, frequently, by nuclear fragmentation (karyorrhexis) (green arrow). (Masson’s trichrome, X400).

Figure 3. Another frequent lesion indicating activity (and therefore permitting classify lesions as class III or IV) is extracapillary proliferation (crescents). In this microphotography we see an almost circumferential epithelial crescent. According to the present classification, crescent must involve at least 25% of the circumference of the Bowman’s space to classify it as extracapillary proliferative lesion (Masson’s trichrome, X400).

Figure 4. Hematoxylin bodies (arrows) are the histologic representation of the LE cells, they are extremely uncommon (approximately found in 2% of biopsies with lupus nephritis) and they are considered as pathognomonic of lupus (H&E, X400).
Histologic classification of lupus nephritis: Due to the importance of histologic changes as indicators of severity and prognosis of the disease and as a direction of the treatment, it is necessary that all we speak a same language and we describe with similar terms the histologic changes to determining better therapeutic approach, to knowing better the evolution of the disease, and to learn more about the physiopathogenic mechanisms. The classification of lupus nephritis has evolved much in the last four decades; from the first proposals in the seventies to today we have learned very much on the correlation between histology and the clinical evolution and treatment response.
The classification of the WHO formulated in 1982 and modified in 1995 was used until 2004, year in which a prestigious group of experts in the theme, including pathologists, rheumatologists, and nephrologists, and supported by the International Society of Nephrology (ISN) and the Renal Pathology Society (RPS) formulated a reviewed classification, based on the accumulated clinical and epidemiological knowledge (Weening JJ, et al, J Am Soc Nephrol 15:241, 2004 [PubMed link]) (Table 1). In addition to this classification, called the ISN/RPS classification, is important to determine index of activity and chronic changes (see below). A proposal to modify this classification was published by a panel of experts in 2018, see below.
| Table 1. Histologic classification of lupus nephritis | |
| WHO (modified, 1995) (Churg et al) | ISN/RPS (published in 2004) (Weening JJ et al) |
| Class I:
Normal glomeruli Class II: Pure mesangial alterations (mesangiopathy) Class III: Focal segmental glomerulonephritis
Class V: Diffuse membranous glomerulonephritis Class VI: Advanced sclerosing glomerulonephritis |
Class I: Minimal mesangial lupus nephritis Class II: Mesangial proliferative lupus
nephritis Class III: Focal lupus nephritis Class IV: Diffuse lupus
nephritis Class V: Membranous
lupus nephritis Class VI: Advanced
sclerosing lupus nephritis |
Modification proposal 2018 (Bajema IM, et al. Revision of the International Society of Nephrology/Renal Pathology Society classification for lupus nephritis: clarification of definitions, and modified National Institutes of Health activity and chronicity indices. Kidney Int. 2018 Feb 16:789-796. [PubMed link]): The proposal of modifications to the previous qualification are summarized as follows: Class II: Definition for mesangial hypercellularity adjusted: Four or more nuclei fully surrounded by matrix in the mesangial area not including the hilar region. The term endocapillary proliferation is replaced by endocapillary hypercellularity (the term proliferation was considered imprecise). The term crescent is used for a lesion consisting of extracapillary hypercellularity, composed of a variable mixture of cells. Fibrin and fibrous matrix may be present; 10% or more of the circumference of Bowman’s capsule should be involved (extracapillary proliferation involving > 25% of the circumference of Bowman’s capsule was the original cutoff). Cellular crescent: more than 75% cells and fibrin and less than 25% fibrous matrix. Fibrous crescent: more than 75% fibrous matrix and less than 25% cells and fibrin. Fibrocellular crescent: 25%–75% cells and fibrin and the remainder fibrous matrix. Adhesion: an area of isolated continuity of extracellular matrix material between the tuft and capsule even when the underlying segment does not have overt sclerosis. Fibrinoid necrosis: fibrin associated with glomerular basement membrane disruption and/or lysis of the mesangial matrix; this lesion does not require the presence of karyorrhexis. Elimination of segmental and global subdivions of class IV. Modification of the NIH lupus nephritis activity and chronicity scoring system (see below) to be used instead of "A", "C", and "A/C" parameters; preference for a semiquantitative approach to describe active and chronic lesions.
For accurate pathologic analysis the tissue should be optimally preserved and processed, and sectioned at multiple levels. Use of special stains is essential for assessment of cellularity and capillary wall alterations. In order to reasonably exclude a focal lesion, the biopsy should contain a minimum of 10 glomeruli for light microscopy analysis; in addition, immunofluorescence (IF) is required for complete renal biopsy study and should include staining for IgA, IgG, IgM, C3 and C1q. With a biopsy adequately processed for light microscopy, with good stains (H&E, methenamine-silver, trichrome, and PAS) and a good IF, it is possible to do an adequate and complete classification of the lupus nephritis, without electron microscopy (EM); even so, it is ideal to have EM like an academic and investigation tool. In cases without IF, EM is essential.
In the ISP/RPS classification are defined, ad hoc, for this classification, some terms, thus: diffuse: >/= 50% of the glomeruli; focal: <50% of the glomeruli; global: >/= 50% of the glomerular tuft; segmental: <50% of the glomerular tuft; Karyorrhexis: presence of apoptotic, pyknotic, and fragmented nuclei; necrosis: fragmentation of nuclei or disruption of the glomerular basement membrane, often associate fibrin-rich material; hyaline thrombi: intracapillary homogenous eosinophilic material which by IF has been shown to consist of immune deposits; crescents: extracapillary proliferation of more than two cell layers occupying 10% or more of the glomerular capsular circumference (in practice, any crescent that is clearly identified as such).
Class I: In class I lupus nephritis, previously (OMS 1995), cases with a complete lack of renal abnormalities by LM, IF, and EM were included, which seemed a contradiction since there is no nephritis. Now this class is reserved for cases without LM alterations, but with immune mesangial deposits by IF or EM (Figure 5).

Figure 5. Lupus nephritis class I characterizes by mesangial deposits of immunoglobulins and/or complement, without morphologic changes by light microscopy. In class II immunopathology can be similar, but there are mesangial proliferative changes. Notice that the deposits are limited to the mesangium and there are not (or they are small and segmental) deposits in capillary walls (direct immunofluorescence for IgG with anti-IgG human antibodies marked with fluorescein, X400).
Class II: Lupus nephritis with mesangial proliferation of any degree (Figure 6). In the previous classification (OMS 1995) cases with severe mesangial proliferation were excluded (they were classified as class IV); now we know that if the mesangial proliferation is severe, with mesangial immune deposits (non extensive and diffuse subendothelial deposits) the clinical behavior is not this of class IV and therefore they must be classified like class II. If there are extensive diffuse subendothelial deposits (by IF or EM) it must be classified like class IV-G. If subendothelial deposits are identified by light microscopy it must be classified like class III or IV depending on the extension of the deposits. Of equal way, the presence of global or segmental sclerosing lesions that are interpreted as sequels of previous glomerulonephritis excludes this category (it would be class III or IV depending on the extension). ).

Figure 6. If we find proliferation of matrix or mesangial cells, the lesion should be classified as class II lupus nephritis. This alteration is accompanied by mesangial immune deposits. The proliferation degree can be severe, but there are not “active” lesions (endocapillary proliferation, karyorrhexis, necrosis…). In this case we can see several mesangial areas with cellular proliferation (arrows). (H&E, X400).
Class III: In this class, usually, the subendothelial deposits are segmental. In assessing the extent of the lesions, both active and sclerotic lesions will be taken into count. Percentage of glomeruli with lesions must be less than 50% to classify the biopsy like class III. In many cases there are also mesangial changes (glomeruli with only mesangial alterations are not included among glomeruli with active or chronic lesions). The glomerular lesions are almost invariably segmental (Figures 7, 8 and 9). For a combined diagnosis of class III and class V is required that membranous changes be identified in 50% or more of the glomerular capillary surface area in at least 50% of the glomeruli (by light microscopy or IF).

Figure 7. In this lupus nephritis case, class III, we can see several segments with endocapillary proliferation (one of them signaled with the green arrow) and two small segments with fibrinoid necrosis in which fuchsinophilic material is identified (red arrows). The necrotizing lesions are associated with a clinical course of severe renal involvement and with greater probability of chronic glomerular changes. (Masson’s trichrome, X400).

Figure 8. In this microphotography we can see a segment of sclerosis and adhesion of the tuft to the Bowman’s capsule (arrows). These alterations must count as chronic lesions and indicate a class III or IV lupus nephritis (C or A/C) according to the number of involved glomeruli. (Masson’s trichrome, X400). ).

Figure 9. In this case we found a segmental chronic lesion (green arrow) that indicates sequels of previous active lesions. Also we can see a zone of fibrosis that arises from the Bowman’s capsule (red arrows) and that suggests a fibrous crescent; this finding also must be classified as chronic lesion, indicating class III or IV lupus nephritis (according to the percentage of involved glomeruli). (Masson’s trichrome, X400).
Class IV: It must have >/= 50% of glomeruli with active or chronic lesions. The lesions can be global or segmental (segmental: <50% of the glomerular tuft). If at least the half of the involved glomeruli have segmental lesions it will be IV-S, and if >/= 50% of glomeruli have global lesions it will be IV-G. If all the lesions are active (endocapillary proliferation, karyorrhexis, necrosis, hyaline thrombi, capillary wall rupture, crescents, or “wire loops”) add the designation (A); if there is at least one chronic glomerular lesion (segmental or global sclerosis) with active lesions, add the designation (A/C); and if all the glomerular lesions are chronic add the designation (C). In many globally sclerosed glomeruli is not possible to determine if the sclerosis was originated by inflammation, these glomeruli must not be classified as chronic lesions for effects to classify the biopsy in class III or IV. This class can be combined with class V, if there is subepithelial deposits (by light microscopy or IF) in 50% or more of the glomerular capillary surface area in at least 50% of the glomeruli. If I have a biopsy with 10 glomeruli and in 4 there are global active lesions and in other 2 segmental sclerosing lesions (6 of 10 with lesions) the biopsy should be classified as class IV-G (A/C), If there are 15 glomeruli and in 5 there are segmental active lesions and 4 global active lesions, this biopsy should be classified as class IV-S (A). Cases of diffuse wire loops with little or no proliferation should be included in the class IV-G (Figures 10 and 11). The IF shows, typically, diffuse subendothelial immune deposits (Figure 13)
In the modification proposal 2018 (Bajema IM, et al. Revision of the International Society of Nephrology/Renal Pathology Society classification for lupus nephritis: clarification of definitions, and modified National Institutes of Health activity and chronicity indices. Kidney Int. 2018 Feb 16:789-796. [PubMed link]): Elimination of segmental and global subdivions of class IV. Modification of the NIH lupus nephritis activity and chronicity scoring system (see below) to be used instead of "A", "C", and "A/C" parameters, preference for a semiquantitative approach to describe active and chronic lesions.

Figure 10. In this case we can see evident subendothelial immune deposits. Left: deposits thickening capillary walls and hyaline thrombi (blue arrows) that correspond to immune aggregates in capillary lumina; they have, although often non-visible, connection with subendothelial deposits and they are not true thrombi. Right. Extensive immune subendothelial deposits, fuchsinophilic (red), in almost all the capillary walls (green arrows). These deposits, demonstrated by light microscopy, indicate class IV lupus nephritis. Many of these deposits are seen as wire loops with H&E stain. The patient of both microphotographies died due to severe SLE and microthrombi in several organs: “catastrophic” antiphospholipid syndrome. (Left: H&E, X400; right, Masson’s trichrome, X400).

Figure 11. The prominent and extensive subendothelial deposits give a rigid aspect to the capillary walls. This finding is denominated “wire loops” (arrows). These findings indicate a class IV lupus nephritis. (H&E, X400).
Class V: Membranous GN. This class can be accompanied by mesangial changes and/or some subendothelial deposits non-visible by light microscopy; if they are demonstrated with this technique must be classified like class V combined with class III or IV depending on its extension. In pure class V there are subepithelial deposits in any extension (segmental or global), identified by light microscopy or IF. In many cases the reaction of the basement membrane is seen as “spikes” (Figure 12). Nevertheless, if there are active or chronic lesions should be diagnosed as class III or IV combined with class V (in these cases it is required that subepithelial deposits [and/or “spikes”] are global and diffuse: in 50% or more of the glomerular capillary surface area in at least 50% of the glomeruli [by light microscopy or IF]). In the new classification Class V does not combine with class I, II nor VI.

Figure 12. Class V lupus nephritis can be seen with similar features to idiopathic membranous GN, nevertheless, most frequently they are accompanied by other proliferative changes in the glomeruli and/or by deposits of C1q and C4 (classic pathway of the complement). See the thickening of the capillary walls and its irregularity due to “spikes” in the external aspect of the basement membranes. (Methenamine-silver, X400).
Class VI: It is diagnosed in those biopsies with global glomerulosclerosis in >/= 90% of the glomeruli and in which there is clinical or pathologic evidence that the sclerosis is attributable to lupus nephritis. This class should be not diagnosed if there is active glomerular disease. In many cases it may be impossible to determine the lupus nephritis class from which the lesions evolved.
In all the cases the extent, severity, and type of tubulointerstitial and vascular disease (tubular atrophy, inflammation, fibrosis, vascular deposits, thrombi, vasculitis, and arterial sclerosis) should also appear in the description and graded in the diagnostic line (at least semiquantitatively: mild, moderate or severe). In some cases the histologic lesions are the result of the presence of antiphospholipid antibodies and we will see thrombotic microangiopathy.
Some authors do not agree with this classification because it minimizes pathological and outcome differences between classes IV-S and IV-G which results in the loss of informational content from the renal biopsies. ISN/RPS does not detect pathogenetic or clinical differences among patients with severe lupus GN (Schwartz MM, et al. The prognosis and pathogenesis of severe lupus glomerulonephritis. Nephrol Dial Transplant. 2008;23:1298-306. [PubMed link]).
Active and chronic lesions: Several system have been formulated to graduate activity and chronicity in lupus nephritis, nevertheless, its utility has been questioned due to poor interobserver reproducibility; in addition, its relevance in therapeutic decisions and prognosis have been variable in different works. An index of activity determined by glomerular and tubulointerstitial changes, assigning numerical values to the lesions to produce an index of activity: 0 to 24, and equal with chronic lesions: 0 to 12, has been the more used scheme (Austin HA et al. Diffuse proliferative lupus nephritis: identification of specific pathologic features affecting renal outcome. Kidney Int. 1984;25:689-95 [PubMed link]); this scoring system was modified in 2018 (Bajema IM, et al. Revision of the International Society of Nephrology/Renal Pathology Society classification for lupus nephritis: clarification of definitions, and modified National Institutes of Health activity and chronicity indices. Kidney Int. 2018 Feb 16:789-796. [PubMed link]) (see below). In this scheme vascular lesions are not considered in the score. This system is used now by some groups, in agreement with their protocols, but its utility in multicentric works or to compare works in different centers is questionable. In many groups this numerical classification is not used.
Proposed modified NIH lupus nephritis activity and chronicity scoring system (Bajema IM, et al. Kidney Int. 2018 Feb 16:789-796. [PubMed link]):
Modified Activity Index Score (0 to 24):
- Endocapillary hypercellularity in <25% (1), 25%–50% (2), or >50% (3) of glomeruli (score: 0-3)
- Neutrophils and/or karyorrhexis in <25% (1), 25%–50% (2), or >50% (3) of glomeruli (score: 0-3)
- Fibrinoid necrosis in <25% (1), 25%–50% (2), or >50% (3) of glomeruli (score 0–3 x 2)
- Wire loop lesions and/or hyaline thrombi in <25% (1), 25%–50% (2), or >50% (3) of glomeruli (score: 0-3)
- Cellular and/or fibrocellular crescents in <25% (1), 25%–50% (2), or >50% (3) of glomeruli (score 0-3 x 2)
- Interstitial leukocytes in <25% (1), 25%–50% (2), or >50% (3) in the cortex (score: 0-3)
Modified Chronicity Index Score (0 to 12):
- Total glomerulosclerosis score, global and/or segmental sclerosis in <25% (1), 25%–50% (2), or >50% (3) of glomeruli (score: 0-3)
- Fibrous crescents in <25% (1), 25%–50% (2), or >50% (3) of glomeruli (score: 0-3)
- Tubular atrophy in <25% (1), 25%–50% (2), or >50% (3) of the cortical tubules (score: 0-3)
- Interstitial fibrosis in <25% (1), 25%–50% (2), or >50% (3) in the cortex (score: 0-3).
More important and reproducible is to determine with precision the total number of glomeruli and to quantify those that have active lesions: how many with crescents (and type: epithelial, fibroepithelial, or fibrous), how many with tuft necrosis, endocapillary proliferation, sclerosis, and so on, and specify if the involvement is global or segmental. In addition, always, determine, at least semiquantitatively (mild, moderate, or severe) tubulointerstitial changes.
In the ISN/RPS classification, the glomerular lesions that define activity are: 1.) endocapillary hypercellularity with or without leukocytes and with substantial diminution of the capillary lumina (Figure 1); 2.) karyorrhexis (Figure 2); 3.) fibrinoid necrosis (Figures 3 and 7); 4.) GBM rupture; 5.) cellular or fibrocellular crescents (Figure 3); 6.) subendothelial deposits identifiable by light microscopy (wireloops) (Figures 10 and 11); and 7.) hyaline thrombi (Figure 10). The glomerular lesions that define chronicity are: 1.) glomerular sclerosis (segmental or global) (Figures 8 and 9); 2.) fibrous adhesions (Figure 8); and 3.) fibrous crescents (Figure 9).
Another classification that has been propose by Hill GS et al (2000) [PubMed link] is more complicated and includes glomerular activity index (GAI): up to 24 points; tubulointersticial activity index (TIAI): up to 21 points; chronic index (CI): up to 15 points, and immunofluorescence index: up to 96 points. Electron microscopy does not contribute to this classification. As we can suppose, this schema is very complex and its reproducibility has not been demonstrated. As expressed by Dr. M. Schwartz (Kidney Int 2000;58:1354-1355 [Free-full text]): "WHO Classification does not utilize all available information in the renal biopsy, but the present study (by Hill GS et al) demonstrates that a detailed pathological analysis, using all available morphological data, does not improve upon either the diagnostic or prognostic value of the histological (WHO) classification at the time of the initial biopsy.
In the interstitium is common to find an inflammatory infiltrate, which is found mainly when there are proliferative lesions (class III and class IV). Isolated tubulointerstitial nephritis in lupus has also been described, with deposits of tubulointerstitial immune complexes; however, in cases of isolated inflammation, it is more frequently associated with drugs. Fibrosis and tubular atrophy may be evidence of previous inflammatory processes and, as in any other kidney disease, should try to quantify because it is a good prognostic factor, which in fact is reflected in the chronicity index.
Vascular lesions: vasculitis (with inflammatory infiltrate) is a well described lesion in lupus nephritis, however it is not very common, and it is associated to high inflammatory activity; lupus vasculopathy (noninflammatory) defined as luminal narrowing of arterioles or terminal interlobular arteries by intramural immune deposits, typically admixed with fibrinoid changes, without inflammation of the vessel wall; isolated immune deposits in arterioles or arteries (only detected by IF) without apparent prognostic implications;thrombotic microangiopathy (TMA) (associated with active lupus, or associated with secondary antiphlophoid syndrome, or other causes); and chronic intimal changes: intimal fibrosis (non-specific).
See Case 150 of our Case Series: TMA in lupus nephritis.
Immunofluorescence
There is immunostaining for IgG in more than 90% of cases; there is IgA and IgM staining in 60-70% of cases. They are accompanied by C3 and C1q in around 80% of cases. C4 is less frequent and staining is weaker. The presence of the three immunoglobulins (Igs) with C3 and C1q is well-known as “full house” pattern, and it is very characteristic of lupus nephritis and very rare in other diseases. The immunostaining varies in agreement with the lupus nephritis class. In classes I and II there are mesangial deposits of Igs and complement; occasional subendothelial deposits may be seen (non diffuse). In class III there are mesangial and capillary wall deposits, many with a segmental distribution, it must not have intense, global and diffuse deposits (it would be class IV). In class IV there are invariably present subendothelial deposits, they are intense, global and diffuse; usually they are accompanied by mesangial deposits. In class V there are diffuse subepithelial granular deposits of IgG and C3, usually accompanied by C1q; it is less frequent to find IgA and C4; mesangial and some small subendothelial deposits can be seen in class V lupus nephritis; the presence of C1q in a membranous GN should generate suspect of a secondary origin, like SLE.

Figure 13. In classes III and IV lupus nephritis there are prominent subendothelial deposits, usually segmental in III, and global and diffuse in class IV. In many cases they are accompanied by immune deposits in the mesangium. The presence of global and diffuse subendothelial immune deposits, even in absence of active lesions by light microscopy, causes that we must classify the case as class IV (proliferative diffuse). (Direct immunofluorescence for IgG with anti-IgG human antibodies marked with fluorescein, X400).
In crescents and necrotizing segments there is immunostaining for fibrin or fibrinogen. It is possible to find deposits of Igs and complement in tubular basement membranes, most of these cases associated to class IV lesions; it is also possible to find subendothelial deposits in small arteries and arterioles.
Electron microscopy
Electron dense deposits are demonstrated with a distribution similar to the one of the immune deposits detected by IF, according to the class. With this technique some small subendothelial deposits, in classes II and V, are more evident; some subepithelial deposits are evidenced in many cases, but they are extensive and predominant only in class V lesions. Some deposits can have an organization in “fingerprint”, there are seen like parallel, regularly curved and spaced deposits, with waved aspect and intersections; these structures are similar to the described ones in cryoglobulinemia and seem to correspond to cryoglobulins. In the cytoplasm of glomerular endothelial cells tubuloreticular inclusions can be seen, they are not specific of lupus nephritis, and they can also be seen in HIV and renal allograft rejection; it is believed that they are an effect of the interferon. In podocytes we can see effacement of podocyte foot processes, similar to the changes seen in other glomerulopathies with nephrotic syndrome. [Tubuloreticular inclusions in cardiomyopathy by interferon - "Figure 1" (link)]
Prognostic markers
Adverse prognostic factors are: presence of nephrotic syndrome, elevation of serum creatinine and BUN in the beginning of the disease, and lack of response to the treatment. Histologic adverse factors include: tubular atrophy and interstitial fibrosis, extensive glomerular sclerosis, and arteritis or necrotizing arteriolitis.
Recurrence of clinically significant lupus nephritis is infrequent after kidney transplantation, near of 2,4%.
See Case 127 of our Case Series (post-transplantation lupus nephritis recurrence).
Lupus Podocytopathy
In 2002, Dube et al. (Dube GK, et al. Minimal change disease in systemic lupus erythematosus. Clin Nephrol. 2002;57(2):120-6. [Pubmed link]) and Hertig et al. (Hertig A, et al.SLE and idiopathic nephrotic syndrome: coincidence or not? Am J Kidney Dis. 2002;40(6):1179-84. [PubMed link]) described small series of patients with SLE, nephrotic syndrome, and biopsy findings of minimal change disease (MCD) or FSGS. Eight of 18 patients in these reports had mesangial deposits, including seven of 11 with MCD and one of seven with FSGS, consistent with concurrent mesangial LN (class I or II). The patients with MCD universally showed rapid remission of nephrotic syndrome with steroid therapy; the response to steroids was inconsistent in patients with FSGS lesions. In 2005, Kraft et al. (Kraft SW, et al. Glomerular podocytopathy in patients with systemic lupus erythematosus. J Am Soc Nephrol. 2005;16(1):175-9. [PubMed link]) reported eight additional patients with SLE, nephrotic syndrome, and light microscopic findings of MCD (i.e., normal appearing), FSGS, or mesangial proliferative GN. Kraft et al. argued that the “development of nephrotic-range proteinuria in patients with SLE without peripheral immune aggregate deposition or endocapillary proliferation on renal biopsy is more likely a manifestation of SLE than the coexistence of idiopathic minimal-change glomerulopathy and SLE”. The term lupus podocytopathy thus arose to describe these lesions as part of the renal involvemement spectrum in SLE. (The previous paragraph taken from: Bomback AS, Markowitz GS. Lupus Podocytopathy: A Distinct Entity. Clin J Am Soc Nephrol. 2016;11(4):547-8. [PubMed link]).
On electronic microscopy, diffuse podocyte foot process effacement in absence of sub-epithelial or sub-endothelial deposition is the morphological feature of lupus podocytopathy. Lupus podocytopathy with glomerular morphology of MCD or mesangial proliferation usually presents with typical nephrotic syndrome and sensitive to glucocorticoid treatment, but the relapse rate could reach up to 90% on maintenance treatment with glucocorticoid alone. Glucocorticoid plus other immunosuppressive agents could significantly decrease the relapse rate. Lupus podocytopathy with FSGS presents with a higher rate of acute kidney injury and less sensitivity to glucocorticoid treatment. The long-term outcomes of lupus podocytopathy are optimistic, but pathological transition could occur after renal relapses (Chen D, Hu W. Lupus podocytopathy: a distinct entity of lupus nephritis J Nephrol. 2018;31(5):629-634. [PubMed link]).
See Case 155 of our Case Series: Lupus podocytopathy.
Renal involvement in rheumatoid arthritis (RA) is not very frequent. The most frequent glomerulopathies associated to RA are membranous GN and pure proliferative mesangial GN; in these cases the appearance by light microscopy, IF, and EM is similar to primary forms of the respective glomerulopathy. Another form of renal injury is secondary amyloidosis. In these cases the lesions are similar to those of any other amyloidosis produced in the context of chronic inflammations, with glomerular, interstitial, and vascular deposits of type AA amyloid (see the corresponding chapter: amyloidosis).
Less frequently associated with RA are membranoproliferative GN and interstitial nephritis. In the disease, systemic necrotizing vasculitis can be found, but renal vessel involvement is not frequent. The presence of rheumatoid nodules in the renal tissue is also unusual; the nodules are formed by granulomas with central necrosis and groups of epithelioid histiocytes that are arranged around of the necrosis areas.
Perhaps more frequent than the previous lesions are renal complications of the RA treatment with gold salts, penicillamine and non-steroid antiinflammatory drugs. In gold salts and penicillamine treatment can appear a secondary membranous GN or, less frequently, proliferative GN, focal and segmental glomerulosclerosis, and tubulointerstitial nephritis. With non-steroid antiinflammatory drugs can appear tubulointerstitial nephritis or, occasionally, minimal change glomerulopathy.
See the Case 25 of our case series.
MIXED CONNECTIVE TISSUE DISEASE
Mixed connective tissue disease (MCTD) is an autoimmune disorder that causes signs and symptoms of other connective tissue diseases. Patients with MCTD experience features of SLE, scleroderma and polymyositis. For this reason, MCTD is sometimes referred to as an overlap disease. Signs and symptoms of these three disorders usually do not appear all at once, this makes diagnosing MCTD somewhat complicated. MCTD occurs most often in women and in young adult, although children have also been diagnosed with MCTD.
This disease has been more completely characterized in recent years and is now recognized to consist of the following core clinical and laboratory features: Raynaud phenomenon, swollen hands, arthritis/arthralgia, acrosclerosis, esophageal dysmotility, myositis, pulmonary hypertension, high level of anti–U1- ribonucleoprotein (RNP) antibodies, and antibodies against U1-70 kd small nuclear ribonucleoprotein (snRNP) (Mixed Connective-Tissue Disease. In e-Medicine, link: www.emedicine.com/med/topic3417.htm).
Renal affectation is evidenced in until 50% of cases. Glomerular lesions can be similar to those of lupus nephritis, being more frequent proliferative mesangial lesions, but lesions of classes III, IV or V may also be seen. Histologic, immunopathologic and ultrastructural aspects are similar to those of lupus nephritis of corresponding class.
Another type of frequent renal lesion is vascular changes similar to those seen in systemic scleroderma (to see below).
PROGRESSIVE SYSTEMIC SCLEROSIS
Also known like scleroderma, diffuse systemic sclerosis, and syndrome CREST. It is a disease with marked thickening of the cutaneous collagen, mainly in distal sites and face, gastrointestinal tract fibrosis, pulmonary fibrosis and cardiovascular alterations. Characteristics of the disease include essential vasomotor disturbances; fibrosis; subsequent atrophy of the skin, subcutaneous tissue, muscles, and internal organs: alimentary tract, lungs, heart, kidney, CNS; immunologic disturbances accompany these findings.
Fibrosis can be caused by profibrotic cytokines, including transforming growth factor-beta (TGF-beta), interleukin-4 (IL-4), platelet-derived growth factor (PDGF), and connective-tissue growth factor. The vasculopathy may be linked to TGF-beta and PDGF, while the diminution of lesional cutaneous blood vessels can be attributed to antiendothelial cell autoantibodies. The activation of the immune system is of paramount importance in the pathogenesis of systemic sclerosis. Antigen-activated T cells, activated infiltrate early, infiltrate the skin, and produce the profibrotic cytokine IL-4. B cells may contribute to fibrosis, as deficiency of CD19, a B-cell transduction molecule, results in decreased fibrosis in animal models (Systemic sclerosis. In: e-Medicine. Link: www.emedicine.com/derm/topic677.htm).
Different factors, including genetic, environmental, vascular, autoimmunologic, and microchimeric factors are involved in systemic sclerosis pathogenesis.
The renal disease in these patients can be acute, by arterial injuries, and chronic due to angiosclerosis. There may be acute renal failure with severe hypertension in 20% of patients. In these cases renal lesions are mainly in interlobular arteries and arterioles; the wall is thickened, with diminution of the lumen, the thickening is mainly intimal, with mixoide or mucinous aspect. Also there may be medial thickening of arteries and arterioles. In some cases there is fibrinoid necrosis of arterial wall. Thrombi may be identified in arterioles. The glomeruli can present endothelial edema and thickening of the capillary walls, sometimes giving an aspect in double contour; also they can have microthrombi, necrotizing lesions and juxtaglomerular apparatus hypertrophy. According to the evolution and lesions type, we can identify infarcts in chronic cases of severe arterial thrombosis or ischemia by arterial occlusion, or tubulointerstitial changes (atrophy and fibrosis). The histologic picture remembers this of hemolytic uremic syndrome.
In chronic lesions we found intimal fibrosis and arteriolar thickening, accompanied of glomerular and tubulointerstitial chronic changes in a variable extension.
In the syndrome CREST (acronym of “Calcinosis, Raynaud' phenomenon, Esophageal dysmotility, Sclerodactyly and Telangiectases”) usually there is few renal involvement.
It is a disorder characterized by inflammation, fibrosis and atrophy of lachrymal and salival glands. It can be associated to other rheumatologic diseases or appear isolated; in many of the patients there are autoantibodies; it has a frank predilection by female sex (M:F: 1:9).
The renal alterations are, mainly, tubulointerstitial changes; there is infiltrated of lymphocytes, plasma cells, and histiocytes. It can have fibrosis and tubular atrophy. Glomerulonephritis (GN) is unusual, and it can adopt a pattern of membranous, membranoproliferative or mesangial proliferative GN.
Main bibliographical sources:
Bibliography
Lupus nephritis
Rheumatoid arthritis
Mixed connective tissue disease
Progressive systemic sclerosis
Sjögren syndrome
Homepage - - - Tutorial Index